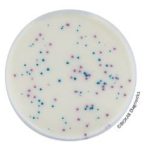
Salmonella Enrichment Salmonella Enrichment
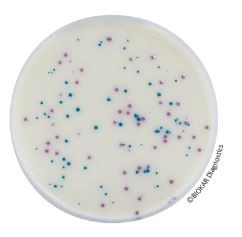
Salmonella Enrichment

Salmonella Enrichment – 500 g bottle
$94.45
Manufacturer: Biokar Diagnostics
Product Code: BK194HA
- Description
- Size Guide
- Vendor Info
- More Products
Description
Salmonella Enrichment – 500 g bottle
Description Of Salmonella Enrichment -500 g bottle
Product Description of IRIS Salmonella® is an alternative research method of Salmonellae in human food and feeds, and environmental sample (except primary production samples).Studies performed on IRIS Salmonella® Agar show a high specificity for the detection of Salmonellae including atypical species and serovars, which is a source of confusion on other medium.Indeed, the detection of Salmonella Typhi and Paratyphi, lactose-positive Salmonellae (Salmonella Senftenberg and subspecies S. arizonae and S. diarizonae), saccharose-positive strains are ensured.The media allows the detection of non-motile serovars (S. Pullorum and S. Gallinarum) or monophasic strains. IRIS Salmonella® Agar allows also the detection of strains which show a light or absence of esterasic activity on other medium (Salmonella bongori, Salmonella Dublin and Atento, certain strains of S. enterica, S. houtenae and S. diarizonae subspecies).IRIS Salmonella® method is officially certified by AFNOR Certification, under the reference number BKR 23/07-10/11, for all human and animal food products and production and production environment samples (excluding primary production environment samples).IRIS Salmonella® is also validated for the detection of Salmonellae in samples from 50 g to 375 g for milk powder, including infant milk with and without probiotics and from 50 g to 125 g for flours and croquettes in animal feedstuffs.
PACKAGING
IRIS Salmonella Agar:
BM16008 – 20 Petri plates Ø 90 mm
BM16108 – 120 Petri plates Ø 90 mm
BK212HA – 500 g bottle
Salmonella Enrichment:
BK194HA – 500 g bottle
Vendor Information
-
Reagents & Standards
TbsRD1 Reagents
$0.00Select options This product has multiple variants. The options may be chosen on the product pageQuick View -